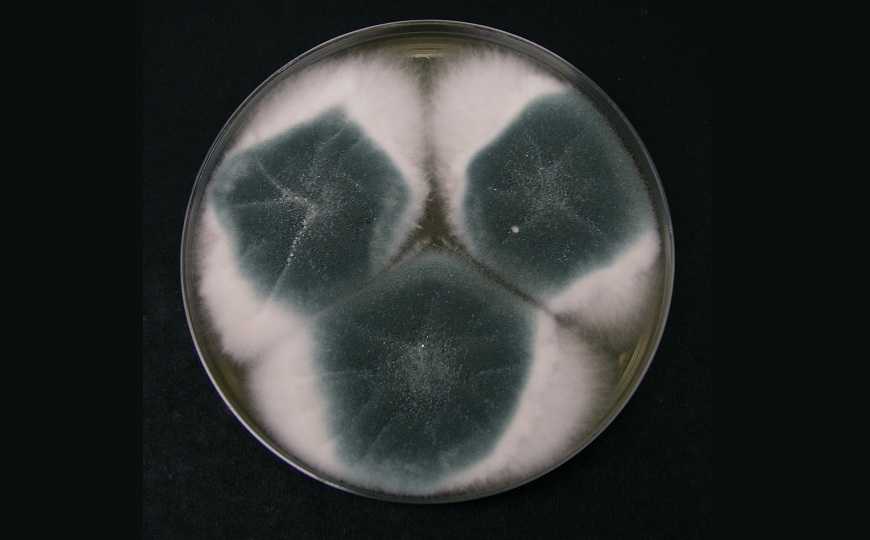

Меченое антитело для неинвазивной диагностики аспергиллеза
Моноклональное антитело к антигену грибка Aspergillus fumigatus, связанное с радионуклидной меткой, позволяет выявлять аспергиллез легких и отслеживать ответ на лечение с помощью ПЭТ/МРТ. Ученые убедились в этом, сравнивая томографическую картину in vivo с результатами микроскопического исследования ex vivo легких, полученных от модельных мышей.
Ученые из Германии и Великобритании разработали метод визуализации грибка Aspergillus fumigatus в легких in vivo, позволяющий не только выявлять аспергиллез, но и отслеживать ответ грибка на терапию. Метод протестировали на мышах.
A. fumigatus — это патоген-оппортунист, широко распространенный в окружающей среде. Его споры переносятся по воздуху и довольно часто попадают в дыхательные пути. Вдыхание спор безопасно для людей с нормально функционирующей иммунной системой, но у пациентов с ослабленным иммунитетом прорастание спор в легких приводит к инвазивному аспергиллезу — быстро прогрессирующему заболеванию с высоким риском смерти. Симптомы аспергиллеза неспецифичны. Это затрудняет диагностику заболевания и ограничивает ее инвазивными методами — анализом биопсийных образцов и БАЛ. Кроме того, в настоящее время не существует достаточно точных методов мониторинга ответа пациентов на лечение.
Ранее ученые показали на мышах, что гуманизированное моноклональное антитело hJF5, специфичное к антигену на поверхности гиф A. fumigatus и конъюгированное с радионуклидной меткой Cu64, делает возможной визуализацию инфекции с помощью ПЭТ/МРТ. В новой работе они проверили, связано ли накопление метки в легких с величиной грибковой нагрузки и можно ли с помощью иммуноПЭТ/МРТ количественно определить ответ на терапию.
Ученые сконструировали антитело hJF5 с двойной меткой: радионуклидной Cu64 и флуорофором. Это позволило им оценивать состояние легких мышей сначала in vivo с помощью иммуноПЭТ/МРТ, затем проверять полученный результат ex vivo с помощью флуоресцентной микроскопии. Для моделирования инфекции на фоне иммуносупрессии использовались мыши с индуцированной нейтропенией.
Мышей интратрахеально заражали A. fumigatus, экпрессирующим красный флуоресцентный белок tdTomato. Меченое антитело вводили внутривенно сразу после заражения. В качестве противогрибкового препарата использовали вориконазол, его вводили через 24 часа после инфекции. ПЭТ/МРТ-исследование легких проводили в двух временных точках, через 24 и 48 часов после заражения. После этого мышей умерщвляли и анализировали распределение грибка и флуоресцентной метки в легких ex vivo микроскопическими методами. Ученые продемонстрировали количественное соответствие между ростом грибка, распределением флуоресцентной метки и распределением радионуклида. Они подтвердили колокализацию двойной метки, связанной с антителом, с очагами роста A. fumigatus на микроскопическом уровне. Вориконазол не оказывал никакого воздействия на распределение антитела. Линейная корреляция между данными ПЭТ/МРТ и результатами микроскопии говорит о возможности точного определения величины грибковой нагрузки.
В следующем эксперименте ученые сравнили с помощью иммуноПЭТ/МРТ ответ на ранний и поздний старт противогрибковой терапии. Мышам вводили вориконазол через 3 и через 24 часа после заражения либо только через 24 часа. Согласно количественным данным, полученным in vivo, через 24 часа после заражения различий в аккумуляции радиоактивной метки для двух групп мышей не наблюдалось. При этом через 48 часов регистрировались выраженные различия: у мышей, получивших вориконазол только на поздней стадии инфекции, поглощение метки усилилось. У мышей, получивших терапию на ранней и поздней стадии, наоборот, поглощение метки в легких значительно уменьшилось.
Таким образом, новый метод позволяет отслеживать инвазивный аспергиллез легких и его ответ на лечение без инвазивных процедур.
«Мы ожидаем, что наша новая метка будет так же хорошо работать в людях, и надеемся, что будущие клинические исследования покажут большое положительное влияние метода на выживаемость при меньшем риске и большем удобстве для пациентов», — говорит главный автор исследования доктор Николас Безьер, сотрудник Отделения доклинической визуализации и радиофармации в больнице Тюбингенского университета.
Источник
Sophie Henneberg, et al. // Antibody-guided in vivo imaging of Aspergillus fumigatus lung infections during antifungal azole treatment. // Nature Communications volume 12, Article number: 1707 (2021); DOI: 10.1038/s41467-021-21965-z
Цитата по пресс-релизу


 Меню
Меню





 Все темы
Все темы




 0
0












